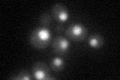
YGR129W
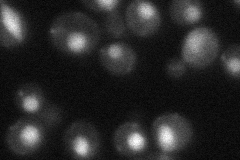
YGR129W

View description
Member of the NineTeen Complex (NTC) that contains Prp19p and stabilizes U6 snRNA in catalytic forms of the spliceosome containing U2, U5, and U6 snRNAs; isy1 syf2 cells have defective spindles activiating cell cycle arrest
Localization:
Intensity:
Fold change:
Significance:
-
C’ GFP library in SD
nucleus37.45 -
N' NOP1pr-GFP in SD

nucleus57.6552 -
N' TEF2pr-mCherry in SD

nucleus56.3987 -
N' NATIVEpr-GFP in SD
nucleus34.1553 -
N' TEF2pr-VC and Cyto-VN in SD

#N/A0 -
C’ GFP library in SD+DTT

nucleus35.70.95No -
C’ GFP library in SD+H2O2

nucleus29.740.79No -
C’ GFP library in Starvation Media

nucleus37.961.01No -
C’ GFP library on the background of Pup2-DaMP

nucleus -
C’ GFP library on the background of CCT mutant

nucleus29.59070.78994No
